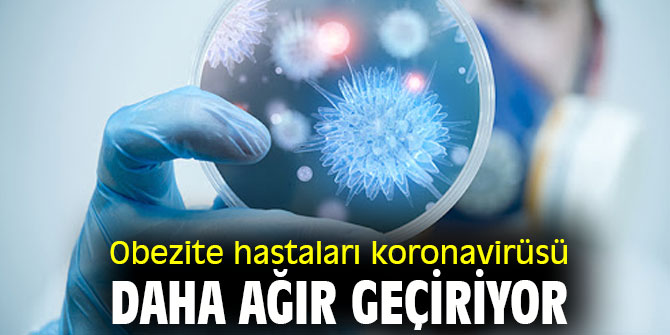

Dikkat! Obezite hastaları koronavirüsü daha ağır geçiriyor
Türkiye Endokrinoloji ve Metabolizma Derneği tarafından düzenlenen “42. Türkiye Endokrinoloji ve Metabolizma Hastalıkları Kongresi”, Covid-19 pandemisi nedeniyle sanal olarak gerçekleştirildi.
Toplantıda konuşan Türkiye Endokrinoloji ve Metabolizma Derneği Başkanı Prof. Dr. Füsun Saygılı, obezitenin günümüzde önlenebilir ölümlerin, sigaradan sonra gelen ikinci en önemli nedeni olduğunu belirterek, “Obezite, diyabet, kalp-damar hastalıkları, hipertansiyon, hiperlipidemi, serebrovasküler hastalık, çeşitli kanserler, obstrüktif uyku-apne sendromu, karaciğer yağlanması, reflü, safra yolları hastalığı, polikistik over sendromu, infertilite, osteoartroz ve depresyon gibi birçok sağlık sorununa neden olur. 2020 verilerine göre dünyadaki erişkin nüfusun %40’ının kilosu normalin üzerindedir. Çocukluk çağında da fazla kiloluluk oranı oldukça yüksek olup %20’dir. Dünya Sağlık Örgütü obeziteyi bir epidemi (yani salgın) olarak tanımlamıştır. Ülkemizde de obezite sıklığı hem yetişkin hem de çocuk ve adolesanlarda giderek artmaktadır. Erişkin nüfusumuzun %32’si obezitesi olan bireylerden oluşur ki bu, Avrupa’daki en yüksek orandır. Obezite, fazladan alınan enerjinin vücutta yağ olarak birikimi sonucu gelişir. Obezite tanım ve derecelendirmesi beden kitle indeksi (BKİ)’ne göre belirlenir. BKİ= Ağırlık (kg)/Boy (m2 ) formülü ile değerlendirilir. BKİ≥30 olması obezite ile uyumludur.” dedi.

OBEZİTE HASTALARI DA ÖNCELİKLİ AŞILAMA GRUBUNA ALINMALI
“Dünyayı yaklaşık 18 aydır etkileyen Covid-19 pandemisi sürecinde yapılan çalışmalar, Covid-19 nedeniyle hastaneye yatanların yaklaşık yarısının obezitesinin olduğunu, başka bir deyişle hastalığın, obezitesi olanlarda yatış gerektirecek denli ciddi seyrettiğini göstermektedir.” diye belirten Saygılı, şöyle devam etti:
“Genel olarak bakıldığında Covid-19 yaşlılarda daha ağır seyretmektedir. Genç olmanın avantajı, obez bireylerde yaşanmamakta; obezitesi olan gençlerde Covid-19 görülme sıklığı artmaktadır. Mayıs 2021 başında yayınlanan bir araştırma, obezitesi olan erkeklerdeki Covid-19 seyrinin obezitesi olan kadınlara göre daha da kötü olduğunu göstermektedir. (BKİ≥35 olan erkekler ile BKİ≥40 olan kadınlarda, normal BKİ sahip bireylerden sırası ile 2.3 ve 1.7 kat daha fazla Covid-19 ile ilişkili ölüm kaydedilmiştir) Obeziteye bağlı komplikasyonlar hastalığın seyrini daha da ağırlaştırmaktadır. Kronik hastalıkları olan kişiler pandemi nedeniyle ihtiyaç duydukları uygun bakımı almakta sorun yaşamaktadır. Obezitesi olan kişilerin pandemi sürecinde karşılaştıkları zorluklar arasında; karantina önlemlerinin fiziksel hareketliliği azaltması, taze ürünler yerine işlenmiş gıdaların daha fazla kullanılması, takiplerinin düzenli gerçekleştirilememesi sayılabilir. Obezitesi olan bireylere, bu süreçte, doğru beslenme ilkeleri, ev içi egzersizler, nefes egzersizleri öğretilmeli, gün ışığına çıkmaları önerilmelidir. Yaşadığımız pandemi için bu grup riskli kabul edilip, aşılamada önceliklendirilebilir.”

TÜRKİYE'DE YAKLAŞIK 20 MİLYON OBEZİTELİ BİREY VAR
Dernek Yönetim Kurulu Üyesi Prof. Dr. Alper Sönmez ise, Türkiye’de obezite tedavisine yönelik sorunlar bulunduğunu söyledi. Ülkemizde yaklaşık 20 milyon obeziteli birey olduğunu, her 3 erişkinden sadece birisinin sağlıklı kilodayken diğer ikisinde kilo fazlalığı veya obezitenin mevcut olduğuna dikkat çeken Sönmez, tedaviyi güçleştiren yaygın kanılara yönelik şöyle konuştu:
“Obezite birçok kronik hastalığın esas nedenidir. Obezite sorununu çözdüğümüz zaman Tip 2 diyabet, hipertansiyon, dislipidemi, koroner arter hastalığı, uyku apnesi, astım, bazı kanserler (özellikle meme, rahim, kolon, pankreas, prostat, böbrek), karaciğer yağlanması ve kronik karaciğer hastalıkları, polikistik over sendromu, depresyon ve daha pek çok kronik hastalığı önleyebiliriz. Obezite, kronik bir hastalık olduğu halde gerek sağlık profesyonelleri gerekse halkımız obeziteyi bir hastalık gibi görmemektedir. Obezite tedavisi deneyimli bir ekibi ve farklı disiplinlerden sağlık profesyonellerinin iş birliğini gerektirir. Obezite hastalarına bilimsel dayanağı olmayan mucize diyetler, mucize bitkiler, mucize ilaçlar veya mucize cerrahi yöntemler önerilmekte, obezite hastaları istismar edilmektedir.”

DİYABET KRONİK VE BULAŞICI OLMAYAN BİR PANDEMİ
Dernek Yönetim Kurulu Üyesi Prof. Dr. Mine Adaş da, diyabet ve Covid-19 denildiğinde salgın içinde salgından söz edilebileceğini belirterek, şu bilgileri verdi:
"Diyabet ve Covid-19 arasında iki yönlü bir etkileşim söz konusudur. Covid-19 diyabetiklerde daha ağır seyretmekte, glisemik kontrolü bozmakta, diyabet ise Covid-19 kliniğini ağırlaştırmaktadır. Diyabet genellikle obezite, hipertansiyon, kalp ve damar hastalıkları ile birliktedir. Diyabetik böbrek hastalığı, diyabetin önemli komplikasyonlarından biridir. Ayrıca kötü glisemik kontrol bağışıklık sistemi üzerine olumsuz etkilidir. Tüm bunlar Covid-19 kliniğinin diyabetiklerde kötü seyretmesinde etkilidir. Bunun yanı sıra Covid-19 pandemisi süresinde evde kapalı kalma, hareket kısıtlılığı, beslenme düzeninin bozulması, strese bağlı hormonların kan şekeri üzerine olumsuz etkileri, Covid-19 tedavisinde kullanılan steroidlerin kan şekerini yükseltmesi ise Covid-19'un diyabet üstüne olan olumsuz etkileridir."
Salgın sürecinde raporlu hastaların ilaçlarına ulaşımında bir sorun yaşamadığını ancak hastalarda bulaş endişesiyle hastaneye başvuruda çekincenin olmasının kontrollerin aksamasına neden olduğunu aktaran Adaş, son dönemde kan şeker kontrolü oldukça bozulmuş olan hastalarla karşılaştıklarını söyledi.










Türkçe karakter kullanılmayan ve büyük harflerle yazılmış yorumlar onaylanmamaktadır.